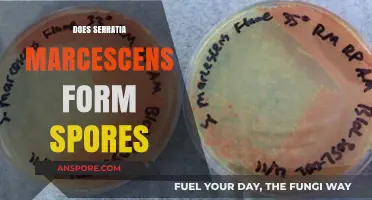
Does Serratia Marcescens Form Spores? Unraveling the Bacterial Mystery

Seed plants, which include gymnosperms and angiosperms, are characterized by their ability to produce seeds as a means of reproduction, distinguishing them from spore-producing plants like ferns and mosses. Unlike these non-seed plants, which disperse through spores to initiate new generations, seed plants rely on seeds to propagate their species. Seeds contain an embryo, stored nutrients, and protective layers, enabling them to survive harsh conditions and disperse over long distances via mechanisms such as wind, water, animals, or mechanical means. While seed plants do not disperse through spores, some primitive seed plants, like cycads and ginkgoes, produce pollen grains that share similarities with spores, but these are used for fertilization rather than as a primary dispersal method. Thus, the reproductive strategies of seed plants are fundamentally distinct from those of spore-dispersing plants, reflecting their evolutionary adaptations to diverse environments.
| Characteristics | Values |
|---|---|
| Dispersal Method | Seed plants do not disperse through spores; they disperse through seeds. |
| Reproductive Structures | Seeds (contain embryo, nutrient storage, and protective coat). |
| Spores in Seed Plants | Spores are produced in the life cycle (e.g., pollen and ovules), but not for dispersal. |
| Dispersal Mechanisms | Wind, water, animals, explosion (e.g., touch-me-nots), or gravity. |
| Examples of Seed Plants | Angiosperms (flowering plants) and gymnosperms (e.g., conifers). |
| Contrast with Spores | Spores are used by non-seed plants (e.g., ferns, mosses) for dispersal and reproduction. |
| Seed Advantages | Seeds provide better protection, nutrient storage, and delayed germination compared to spores. |
| Life Cycle Stage | Spores are part of the alternation of generations in seed plants but are not the primary dispersal unit. |
| Adaptations for Dispersal | Seeds have adaptations like wings, hooks, or fleshy fruits to aid dispersal. |
| Ecological Role | Seeds ensure survival in harsh conditions and long-distance colonization. |
Explore related products
What You'll Learn

Seed vs. Spore Dispersal Mechanisms
Seed plants, such as gymnosperms and angiosperms, rely on seeds for reproduction, while spore-producing plants like ferns and mosses use spores. This fundamental difference in reproductive structures dictates distinct dispersal mechanisms, each adapted to the plant's life cycle and environmental challenges. Seeds, encased in protective coats, are typically larger and more resource-intensive to produce, whereas spores are microscopic, lightweight, and produced in vast quantities. This contrast in size and structure directly influences how these reproductive units are dispersed, with seeds often requiring external agents like animals or wind for short-distance travel, and spores leveraging their minuscule size for wind-driven, long-distance dispersal.
Consider the dispersal of dandelion seeds versus fern spores. Dandelions employ a pappus—a feathery structure attached to the seed—that acts as a parachute, allowing wind to carry seeds short distances. In contrast, fern spores are released in enormous numbers from the undersides of fronds, forming a fine dust that can be carried by the slightest air current for miles. This example highlights the trade-off between precision and volume: seeds are dispersed sparingly but with higher survival potential due to their nutrient reserves, while spores are scattered widely, relying on sheer numbers to ensure at least some land in favorable conditions.
From a practical standpoint, understanding these mechanisms can inform gardening and conservation efforts. For instance, when propagating spore-based plants like ferns, create a humid environment and scatter spores on moist soil, mimicking their natural dispersal and germination conditions. For seed plants, such as wildflowers, sow seeds in areas with adequate sunlight and water, and consider using seed balls—clay-coated seeds—to protect them from predators and ensure gradual dispersal during rain. Both methods capitalize on the inherent dispersal strategies of these plants, increasing the likelihood of successful growth.
A comparative analysis reveals that spore dispersal is inherently riskier but more opportunistic. Spores’ small size and lack of nutrient storage mean most will perish, but their sheer quantity and ability to travel vast distances increase the odds of colonization in new habitats. Seeds, on the other hand, are a high-investment, low-volume strategy, with each seed equipped to germinate and grow independently. This difference underscores the evolutionary trade-offs between survival through volume (spores) and survival through resilience (seeds), shaping the ecological niches these plants occupy.
In conclusion, the dispersal mechanisms of seeds and spores reflect their distinct biological strategies. Seeds prioritize protection and resource allocation, relying on external agents for localized spread, while spores exploit their size and abundance for wide-ranging dispersal. By studying these mechanisms, we gain insights into plant ecology and practical tools for horticulture and conservation, ensuring the survival and propagation of diverse plant species in their respective environments.
Can Mold Spores Trigger Acne Breakouts? Uncovering the Hidden Link
You may want to see also

Role of Wind in Seed Plant Dispersal
Wind plays a pivotal role in the dispersal of seeds for many plant species, a process known as anemochory. Unlike spore dispersal, which is characteristic of non-seed plants like ferns and fungi, seed plants have evolved diverse mechanisms to ensure their offspring travel beyond the parent plant. Wind dispersal is particularly effective for plants in open habitats where air currents are consistent. Seeds adapted for wind travel often feature lightweight structures such as wings, bristles, or parachutes. For instance, maple trees produce samara seeds with wing-like extensions that allow them to glide through the air, increasing their dispersal range. Similarly, dandelion seeds are equipped with feathery pappi that act as tiny parachutes, enabling them to be carried over long distances by even gentle breezes.
To maximize wind dispersal, plants often release seeds in large quantities, increasing the likelihood that at least some will land in favorable environments. This strategy is especially critical for colonizing new areas or recovering from disturbances. For example, pine trees release thousands of lightweight, winged seeds that can be carried for miles, ensuring that a few will find suitable soil to germinate. However, this method is not without its challenges. Wind dispersal is highly dependent on weather conditions, and seeds may end up in unsuitable locations, such as water bodies or rocky terrain, where they cannot survive.
Practical considerations for gardeners and conservationists include understanding wind patterns to predict seed movement. Planting wind-dispersed species on the windward side of a garden or restoration site can enhance their spread. Additionally, timing seed release with seasonal winds can improve dispersal efficiency. For instance, planting cottonwood trees in spring, when winds are typically stronger, can aid in their natural propagation. Caution should be exercised with invasive species that rely on wind dispersal, as their seeds can quickly dominate an area, outcompeting native flora.
Comparatively, wind dispersal differs significantly from spore dispersal in terms of seed size, structure, and energy investment. While spores are microscopic and produced in vast numbers, seeds are larger and require more resources to produce. However, seeds have the advantage of containing stored nutrients, giving seedlings a head start in growth. Wind-dispersed seeds also often have mechanisms to delay germination until they reach a suitable site, such as hard seed coats or dormancy periods. This adaptability highlights the evolutionary sophistication of seed plants in utilizing wind as a dispersal agent.
In conclusion, the role of wind in seed plant dispersal is a testament to the ingenuity of plant adaptations. By leveraging lightweight structures and strategic timing, plants ensure their seeds travel far and wide, increasing their chances of survival and reproduction. For those working with plants, understanding these mechanisms can inform better practices in gardening, agriculture, and conservation, ensuring the successful propagation of desired species while mitigating the spread of unwanted ones.
How Do Bryophytes Disperse Spores? Exploring Their Unique Reproduction Methods
You may want to see also

Animal-Assisted Seed Dispersal Methods
Seed plants, unlike ferns and fungi, do not disperse through spores; instead, they rely on seeds as their primary means of reproduction. However, the journey of these seeds from parent plant to new habitat often hinges on animal assistance, a process both intricate and vital. Animals act as unwitting couriers, transporting seeds in ways that ensure their survival and dispersal across diverse ecosystems. This symbiotic relationship highlights the interconnectedness of flora and fauna, showcasing how evolution has crafted strategies for plant propagation that leverage animal behavior.
Consider the mechanism of endozoochory, where animals ingest seeds that pass through their digestive systems unharmed. Birds, mammals, and even fish consume fruits, inadvertently carrying the seeds within. For instance, the vibrant red berries of yew trees are a favorite of thrushes, which excrete the seeds in nutrient-rich droppings, enhancing germination rates. Similarly, elephants disperse the seeds of figs over vast distances, their dung serving as a fertile bed for new growth. This method not only disperses seeds but also provides them with a natural fertilizer, illustrating nature’s efficiency.
Another critical method is epizoochory, where seeds attach to an animal’s fur, feathers, or skin. Burdock plants, with their hooked seeds, are a classic example. These seeds cling to passing animals, hitching a ride to new locations. Similarly, the spines of unicorn plant seeds attach to deer or livestock, ensuring dispersal across grazing areas. While less common than endozoochory, this method is particularly effective in open habitats where animals roam freely. For gardeners or conservationists, mimicking this process by strategically placing seed-bearing plants near animal trails can enhance natural dispersal.
Humans, too, play a role in animal-assisted seed dispersal, albeit often unintentionally. Domesticated animals like cattle and sheep carry seeds on their coats or in their digestive systems, spreading them across pastures and beyond. Urban areas also contribute, as birds and rodents transport seeds from gardens to parks or rooftops. This anthropogenic aspect underscores the complexity of seed dispersal networks in modern ecosystems. For those interested in restoring native plant populations, encouraging wildlife corridors or planting fruit-bearing species can amplify animal-assisted dispersal efforts.
In conclusion, while seed plants do not disperse through spores, animal-assisted methods provide a dynamic and effective alternative. From the digestive tracts of birds to the fur of mammals, animals serve as essential partners in plant reproduction. Understanding these mechanisms not only deepens our appreciation for ecological relationships but also offers practical insights for conservation and horticulture. By fostering environments that support these interactions, we can ensure the continued spread and survival of plant species in an ever-changing world.
Inhaling Spores: Uncovering the Hidden Health Risks and Causes
You may want to see also
Explore related products
$13.99 $17.99

Water as a Seed Dispersal Medium
Water serves as a powerful yet often overlooked medium for seed dispersal, particularly in aquatic and riparian ecosystems. Unlike spores, which are typically associated with non-seed plants like ferns and fungi, seeds are the reproductive units of flowering plants and gymnosperms. However, both seeds and spores share the need for effective dispersal mechanisms to ensure survival and colonization. Water’s role in seed dispersal is especially critical for plants in wetland, coastal, and riverine environments, where it acts as a natural conveyor belt, transporting seeds over vast distances with minimal energy expenditure from the parent plant.
Consider the coconut (*Cocos nucifera*), a prime example of water-mediated seed dispersal. Its buoyant, fibrous husk allows it to float across oceans for months, sometimes traveling thousands of kilometers before washing ashore and germinating. This adaptation ensures the species’ survival in isolated island ecosystems. Similarly, mangroves like *Rhizophora mangle* produce viviparous seedlings (propagules) that can float in seawater for weeks, enabling them to colonize new mudflats and stabilize coastal shorelines. These examples highlight water’s dual role as both a transport medium and a selective pressure, favoring seeds with traits like buoyancy, durability, and salt tolerance.
To harness water as a seed dispersal medium in restoration projects, follow these steps: First, select species with seeds adapted to water transport, such as *Salix* (willow) or *Alnus* (alder) for riparian zones. Second, time seed release to coincide with seasonal floods or high tides, maximizing dispersal range. Third, protect seeds from predators and abrasion by using mesh bags or biodegradable coatings. Caution: Avoid introducing invasive species, as water dispersal can inadvertently spread aggressive colonizers like *Phragmites australis*. Monitor dispersal patterns using GPS trackers or dye markers to assess effectiveness and adjust strategies accordingly.
Comparatively, water dispersal differs from wind or animal-mediated methods in its unpredictability and scale. While wind dispersal relies on lightweight seeds and animal dispersal on attractive fruits, water dispersal demands seeds that can withstand prolonged submersion and varying salinity levels. This makes it a high-risk, high-reward strategy, particularly in dynamic environments like floodplains and deltas. For instance, the seeds of *Nelumbo nucifera* (sacred lotus) can remain viable in sediment for decades, germinating only when water levels recede, a testament to their resilience in aquatic ecosystems.
In conclusion, water is a vital yet underappreciated seed dispersal medium, offering unique advantages for plants in aquatic and transitional habitats. By understanding its mechanisms and limitations, ecologists and conservationists can leverage water dispersal to restore degraded ecosystems and enhance biodiversity. Whether through natural processes or assisted methods, water’s role in seed transport underscores its importance in the life cycles of countless plant species, bridging the gap between terrestrial and aquatic worlds.
Detecting Mold Spores: A Comprehensive Guide to Air Quality Testing
You may want to see also

Human Impact on Seed Dispersal Patterns
Seed plants, unlike ferns and fungi, do not disperse through spores; they rely on seeds for reproduction. However, human activities have significantly altered the natural patterns of seed dispersal, creating both challenges and opportunities for plant ecosystems. Urbanization, deforestation, and agriculture fragment habitats, disrupting the movement of seeds by wind, water, and animals. For instance, the construction of roads and cities often isolates plant populations, reducing genetic diversity and making species more vulnerable to diseases and climate change.
Consider the role of animals in seed dispersal. Many plants depend on birds, mammals, and even ants to carry their seeds to new locations. Human-induced declines in animal populations, such as the loss of pollinators and seed-dispersing birds, directly impact this process. For example, the near-extinction of the passenger pigeon in North America removed a key disperser for oak and hickory trees, altering forest composition. To mitigate this, conservationists recommend creating wildlife corridors and restoring native habitats to reconnect fragmented ecosystems.
Agriculture, while essential for human survival, often homogenizes landscapes, replacing diverse plant communities with monocultures. This reduces opportunities for natural seed dispersal and increases reliance on human-mediated methods, such as mechanical planting. However, agroecological practices like intercropping and the use of hedgerows can reintroduce diversity, supporting both crop yields and native plant species. Farmers can incorporate these strategies by planting native trees along field edges or integrating cover crops that attract seed-dispersing insects.
Climate change, exacerbated by human activities, further complicates seed dispersal patterns. Shifts in temperature and precipitation alter the timing of seed release and the behavior of dispersers. For example, migratory birds may arrive too late to disperse seeds for plants that have already flowered. To address this, land managers can focus on planting species with flexible phenologies or those adapted to a wider range of conditions. Additionally, seed banks can preserve genetic material for future restoration efforts, ensuring resilience in the face of uncertainty.
Finally, human-assisted seed dispersal, while sometimes necessary, carries risks. Intentional or accidental introduction of non-native species can outcompete native flora, disrupting ecosystems. For instance, the spread of kudzu in the southeastern United States, originally planted for erosion control, has smothered native vegetation. When engaging in seed dispersal efforts, individuals and organizations should prioritize native species and conduct thorough risk assessments. Practical tips include sourcing seeds locally, avoiding invasive species, and collaborating with ecologists to ensure long-term ecological benefits.
Ringworm Spores: Uncovering the Truth Behind Fungal Infections
You may want to see also
Frequently asked questions
No, seed plants (gymnosperms and angiosperms) do not disperse through spores. They reproduce and disperse via seeds.
The primary method of dispersal for seed plants is through seeds, which are produced from the fertilization of ovules and are often dispersed by wind, water, animals, or other means.
Non-seed plants, such as ferns, mosses, and fungi, disperse through spores, which are lightweight, unicellular structures capable of developing into new plants under suitable conditions.
Seed plants do not produce spores as part of their reproductive cycle. Spores are characteristic of non-seed plants and some lower plant groups, not seed plants.
Seed plants rely on seeds because they provide a more protected and nutrient-rich environment for the developing embryo, increasing the chances of survival and successful germination in diverse environments.